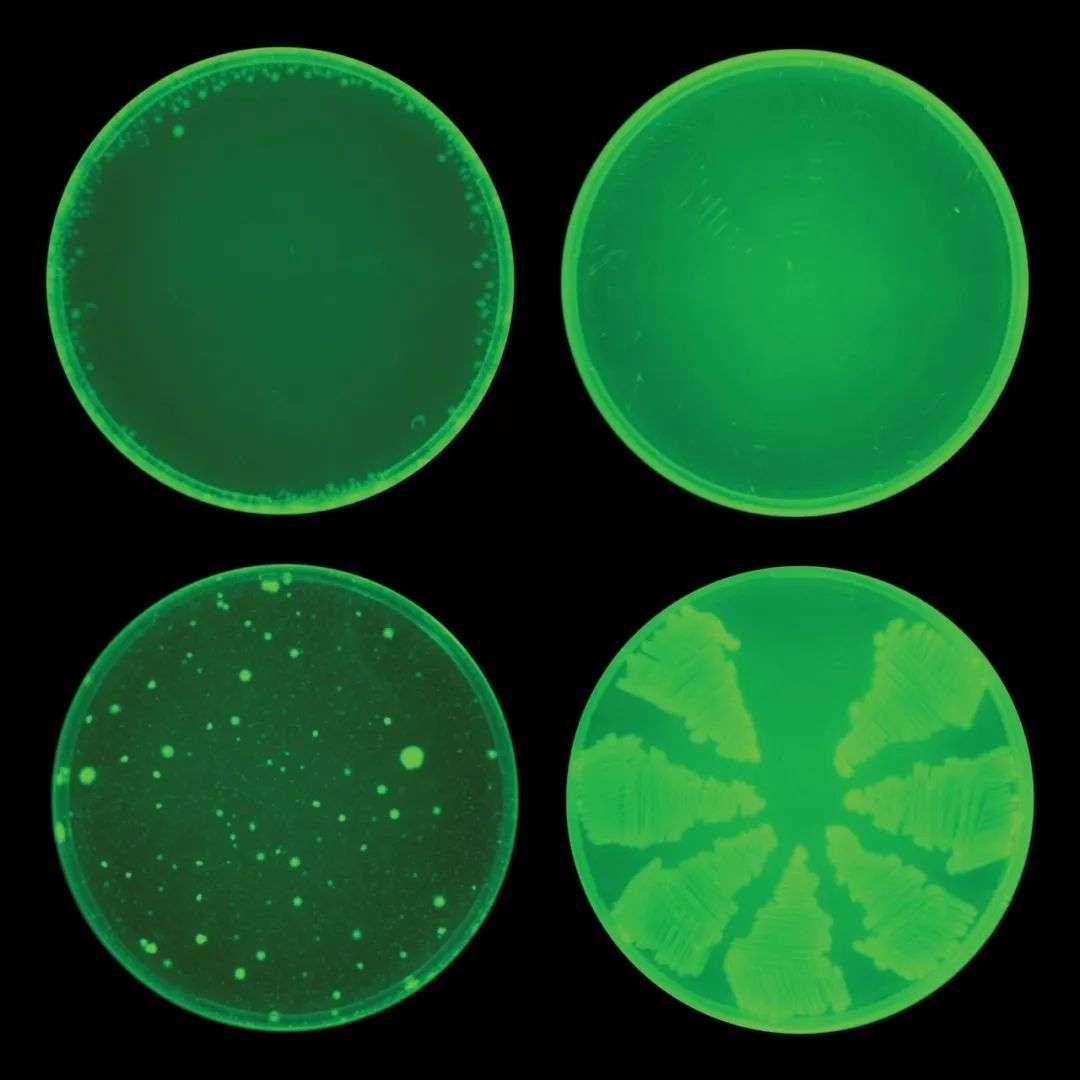

AI发现超级抗生素,多种抗药性细菌的克星出现了
编者按:本文来自微信公众号“造就”(ID:xingshu100),36氪经授权发布。
作者 | 尹欢欢
版面 | 田晓娜
随着细菌对药物免疫力的逐步进化,强大的抗生素正以惊人的速度失去疗效。全世界每年至少有70万人死于以前可以用抗生素治疗的疾病。
联合国抗微生物药物耐药性机构的一份报告显示,如果到2050年还未取得新的重大进展,那么死亡率可能从每年70万上升至1000万。
日前,科学家在《细胞》杂志宣布,他们借助强大的深度学习算法,发现了一种全新的抗生素,它非常规的机能可以对抗对多种有抗药性的感染。
借助深度学习算法,科学家们发现了新的抗生素
使用计算机和机器学习来理解大量的生物医学数据本不是什么新鲜事。但是,这次由詹姆斯·柯林斯(James Collins)领导的麻省理工学院研究小组和人工智能研究人里贾纳·巴兹利(Regina Barzilay)领导的研究小组,通过开发一种神经网络,避免了科学家对潜在药物的成见,筛选并发现了新的抗生素。
麻省理工学院的工程学教授柯林斯
柯林斯表示,借助深度学习,你将可以识别出那些不常见的抗生素分子,或许还可以合成出一些新的化学物质。
抗生素使用和开发均遭遇困境
自亚历山大·弗莱明(Alexander Fleming)从真菌中获得第一种抗生素以来,大自然一直是我们抗菌药物的灵感库。但抗药性的升高是所有抗生素目前面临的问题。与此同时,通过筛选天然化合物来识别抗生素的传统方法明显耗时且昂贵,因此科学家们正在寻找新的解决办法。
为了缩小搜索范围,研究人员试图了解细菌如何生存和繁殖,然后寻找攻击这些过程的化合物(例如破坏细菌的细胞壁、阻止细菌的繁殖、抑制其蛋白质的产生等)。
但是,即使在20世纪80年代引入了计算机辅助的高通量筛选方法,在随后的几十年中,抗生素开发的进展依然很慢。
主要原因有二,其一,有时筛选出的结果与现有抗生素太相似,无法有效抑制抗药细菌;其二,由于成本高且效率低,很多制药公司选择更有利可图的慢性病药物,而放弃抗生素的开发。
深度学习降低了抗生素开发难度
此次,科学家们根据人类大脑神经元的表现,让机器对其进行深度学习,从而筛选且发现了新的抗生素(传统的计算机程序可能会筛选一个分子库,以找到某些定义的化学结构,但神经网络可以训练,以自行了解哪些结构特征可能有用并找到它们)。
这其中最关键的一环是柯林斯、巴兹利及其团队训练给机器提供足够质量的训练数据。比如,他们期望找到任何能抑制大肠杆菌生长的化合物。为此他们向系统提供了一个2300多个化合物的已知分子结构,由于由于训练数据库中只有大约10%的化合物是已知的抗生素,因此神经网络不会因为抗生素分子应该如何工作或它们应该是什么样子的假设而产生偏差。
当然,抑制细菌的能力并不是唯一重要的标准(比如:氰化物和砷也可以杀死一些细菌,但这不会使它们成为有用的抗生素),因此,研究人员还训练该算法来预测化合物的毒性,并在此基础上删除候选分子。
里贾纳·巴兹利
宾夕法尼亚大学佩雷尔曼医学院生物工程、微生物学和精神病学的教授德拉富恩特(César de la Fuente)说:“新的算法已经获得FDA批准,且很快会用于临床测试。”
柯林斯、巴兹利及其团队将其智能的“抗菌性神经网络筛查”与“毒性筛查”相结合,然后删除了他们认为与现有抗生素过于相似的化合物(因为细菌可能已经对其产生了抗药性)。
最终,他们认为最有可能出现的一种药物候选物是c-Jun N端激酶抑制剂SU3327(可能对于糖尿病的治疗很有用),研究人员将这种化合物命名为halicin。
实验室的检测显示,halicin不仅有效地阻止了大肠杆菌的生长,而且还杀死了其他细菌,包括结核分枝杆菌(结核病的原因),艰难梭菌(会引起胃肠道疾病)和引起败血症、肺炎、伤口感染和其他常见的难治性感染的多种其他抗药性细菌。
尽管大多数抗生素在经过几天的实验室测试后就产生了抗药性提示,但在反复接触一个月后,halicin没有产生抗药性大肠杆菌突变体。
最上面两个培养皿均用盐蛋白处理,下面两个则是用常规抗生素环丙沙星处理,两排的后者是通过神经网络识别的新型抗生素。由于这些细胞似乎没有对halicin产生抗性,因此在顶层两个培养皿中的细菌生长会大大降低
使用同样受过训练的深度网络,进一步筛选更大的化合物集合,人们有希望发现别的潜在抗生素。
匹兹堡大学生物科学助理教授雅各布·杜兰特(Jacob Durrant)说:“以前想要一次性对超过1亿多种化合物进行抗生素活性物理测试的想法非常荒谬,但是该算法能够在短短四天内对所有这些分子进行排名,将范围缩小到只有23个有希望的物理测试竞争者,这太神奇了。”
AI发明抗生素的时代已经到来?
很多新闻开始宣告AI发明抗生素的时代已经到来,但是作为机器学习专家的巴兹利表示,没有人类细致的工作与思考,机器是做不到这点的,因此不能说是新抗生素是AI发明的,只是它帮助人类筛选出了更多可用信息。
柯林斯对此表示赞同,并指出,如果没有人类选择高质量的训练数据,即使是再强大的算法可能也无法达到效果或者带有偏见。
目前用于培训深度网络寻找新型抗生素的有效数据有限
此外,不只一位研究人员提醒说,目前用于培训深度网络寻找新型抗生素的有效数据有限,这给今后的工作进展带来了障碍。
尽管表面上看,深度网络学习在发现抗生素方面有很大成效,且柯林斯预测计算机算法的准确率很快将会从目前的51%提升至90%,但计算机工作还是无法代替实验、临床测试。因此,人类研究人员只能将这些算法视为新工具,继续探索看不见的潜在药理学和深层分子环境。
该领域最终成功的标志之一就是AI可以发现、创造出真正的抗耐药性的抗生素,这也是德拉富恩特实验室目前正在开展的项目之一。
他表示,作为一个微生物学家,我非常尊重细菌,也坚信我们能在这场军备竞赛中跟上它们的步伐。